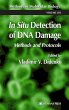

In Situ Detection of DNA Damage
Methods and Protocols
Herausgegeben: Didenko, Vladimir V.
Versandkostenfrei!
Versandfertig in 1-2 Wochen
77,99 €
inkl. MwSt.

PAYBACK Punkte
39 °P sammeln!
Detection and analysis of DNA damage is of critical importance in a variety of biological disciplines studying apoptosis, cell cycle and cell di- sion, carcinogenesis, tumor growth, embryogenesis and aging, neu- degenerative and heart diseases, anticancer drug development, environmental and radiobiological research, and others. Individual cells within the same tissue or in cell culture may vary in the extent of their DNA damage and, consequently, can display different re- tions to it. These differences between individual cells in the same cell popu- tion are detected using in situ approaches. ...
Detection and analysis of DNA damage is of critical importance in a variety of biological disciplines studying apoptosis, cell cycle and cell di- sion, carcinogenesis, tumor growth, embryogenesis and aging, neu- degenerative and heart diseases, anticancer drug development, environmental and radiobiological research, and others. Individual cells within the same tissue or in cell culture may vary in the extent of their DNA damage and, consequently, can display different re- tions to it. These differences between individual cells in the same cell popu- tion are detected using in situ approaches. In situ is a Latin term meaning "on site" or "in place." It is used to denote the processes occurring or detected in their place of origin. In mole- lar and cell biology this usually refers to undisrupted mounted cells or tissue sections. In that meaning "in situ" is used as part of the terms "in situ PCR," "in situ transcription," "in situ hybridization," "in situ end labeling," and "in situ ligation." Sometimes the "in situ" term is applied at the subcellular level to cells disrupted in the process of analysis, for example, in the detection of specific sequences in chromosomes using fluorescent in situ hybridization (FISH). Historically, the term was used primarily in methods dealing with nucleic acids.